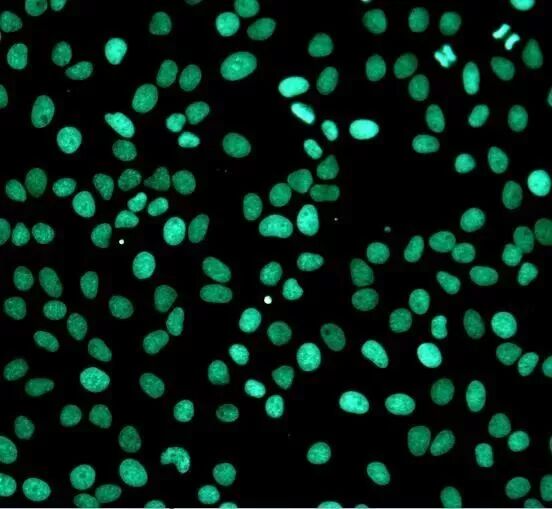
ͼƬ

| 一、TUNEL法的实验原理
细胞凋亡中, 染色体DNA双链断裂或单链断裂而产生大量的粘性3'-OH末端,可在脱氧核糖核苷酸末端转移酶(TdT)的作用下,将脱氧核糖核苷酸和荧光素、过氧化物酶、碱性磷酸酶或生物素形成的衍生物标记到DNA的3'-末端,从而可进行凋亡细胞的检测,这类方法称为脱氧核糖核苷酸末端转移酶介导的缺口末端标记法(terminal -deoxynucleotidyl transferase mediated nick end labeling, TUNEL)。由于正常的或正在增殖的细胞几乎没有DNA的断裂,因而没有3'-OH形成,很少能够被染色。由此,TUNEL成为了检测DNA片段化(细胞凋亡)的最常用方法。(以下是TUNEL法细胞凋亡检测试剂盒(绿色荧光))
TUNEL检测:使用10 U/ml Dnase处理Hela细胞10分钟
二、TUNEL实验中关键步骤
1.充分脱蜡和水化。脱蜡可以先 60oC 20 min,再用使用二甲苯两次 5-10 min;而水化用梯度乙醇从高浓度到低浓度浸洗,这些以便后面的结合反应充分、均匀;
2.把握好细胞通透的时间。一般根据切片的厚薄,选择蛋白酶k的孵育时间,常用 10-30 min,几 μm 切片用短时间;几十 μm 切片用长时间,通过摸索达到既不脱片,有能够使后面的酶和抗体进入胞内。
3.适当延长 TUNEL 反应液的时间。一般是37oC 1 h,你也可以根据你的凋亡损伤程度,选择更长的时间,可长至 2 h,但要结合你最终的背景着色。
4.DAB 显色条件的选择。一般 DAB 反应10 min 左右,结合镜下控制背景颜色,最长不超过 30 min;promega 公司提供的 DAB 液(桃红色),不利于辨认棕褐色,我不太喜欢。
5.PBS 的充分清洗。我个人认为,在 TUNEL 反应后和酶标反应后的清洗应十分严格,可增加次数达 5 次,因为这些清洗直接决定最后切片的非特异性着色。
6. 此外,内源性 POD 的封闭也十分关键。对于肝脏、肾脏等血细胞含量多的组织,我的经验是适当延长封闭时间和升高过氧化氢的浓度,可以达到很好的封闭效果,且不影响最终的特异性染色。
三、细胞通透的时间选择
1.蛋白酶 k 的目的是通透细胞膜和核膜,从而使反应试剂充分进入细胞核进行反应,提高阳性率。但浓度过高或孵育时间太长容易脱片,只要不脱片,好像影响不大,其作用类似与 TritonX100 等细胞通透剂。
2. 蛋白酶K一般工作液浓度为 20 μg/ml,但浓缩液可配制1-10 mg/ml,可用 PBS 配制,也可用蛋白酶K缓冲液(100 mM Tris HCl pH8.0+50 mM EDTA);然后分装成小份,用完一支再用下一支,-20oC保存 1 个月应该没问题的(重复拿的那支),而一直冷冻的至少可以用半年以上。
3. 蛋白酶K反应时间一般为10-30 min,具体时间长短与切片厚薄有关,4 μm左右的片子可以用 10 min,但30 μm左右的可用30 min,最终通过摸索最佳时间。过长易脱片、过短起不到通透效果。
关键试剂操作条件
DAB 显色反应大约需要10 min,要控制好反应时间,勿使背景颜色过深。具体的可能还是得根据切片组织来源和切片厚度、试剂盒种类不同来摸索一下。
蛋白酶K工作液处理时间、温度须在范围内摸索,温度过高,时间过长,易破坏核酸结构,出现假阳性。
DNase 1 一般室温,10 min 即可。
四、如何减弱非特异性染色
若是肝脏或肾脏,因富含内源性过氧化物酶,需要增加过氧化氢浓度和延长孵育时间。其他还可以加强灭活、缩短 DAB 孵育时间、PBS 充分清洗,注意镜下把握好着色。
注意:
1.湿盒用带盖方盘,里面固定几根玻璃吸管用于放玻片,使用时稍加水即可。
2.英文说明书中对组织细胞通透这一步中,加了“对难处理的组织的处理”,意思是用常规方法处理(如蛋白酶 K)后,应该阳性而做不出阳性时,可用微波修复。
3.复染的目的是为了衬托组织形态结构,以利于结果分析,石蜡切片常用苏木素,核染成兰色,冷冻切片常用甲基绿,核染成绿色。
4.PBS 用蒸馏水、Na2HPO4、KH2PO4配制,现在有卖的,自己加蒸馏水稀释后即可用,很方便,也不贵。
5.蛋白酶 K 消化蛋白后,需要用封闭液。
|